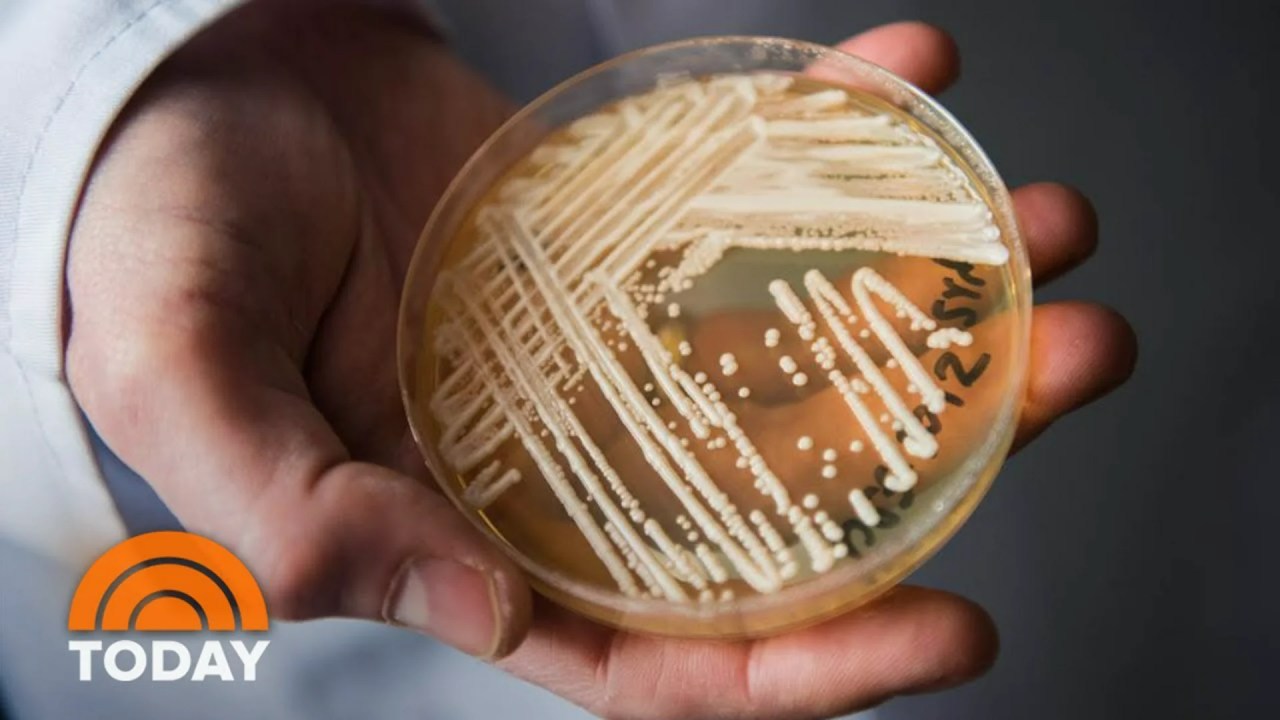

All Our Documentaries
Are you looking for an engaging and captivating way to learn about the world we live in?
Look no further than Documentarytube! Our library of free documentaries offers a wide range of topics that will spark your curiosity.
From current events and social issues to history and culture, you can explore each subject on your own terms. Whether you want to stay up-to-date on the latest trends or discover something a little off the beaten path, Documentarytube has you covered.
Browse our selection of trending and popular documentaries to stay ahead of the curve, or explore individual categories for an even more unique and personalized experience.


Kings of the stage: the drag acts rewriting the rules of masculinity
Deadly bacteria and the pharmaceutical industry

Is Religion A Force For Good In The World?

Style Wars 1983

Steps of Autopsy Dissection

Winged Migration

Amazing Animals With Unusual Superpowers

Top 5 Artifacts That PROVE Past Advanced Civilizations Existed

The rise of Dwayne Wade

How to Kill a Human Being

My Son The Pornographer

How Will We Love?

Mo Farah – Race of His Life

The Buddha

Hunting Pablo Escobar

Believeland – Cleveland Cavaliers and LeBron James Documentary

Gambling on Addiction : How Governments Rely on Problem Gamblers

What Plants Talk About

The Amsterdam Red Light District

Congo, My Precious. The Curse of the coltan mines in Congo

Anonymous Documentary – How Anonymous Hackers Changed the World

Ancient Greeks: Golden Age of Civilization
Discover more
Popular best-of lists
10 Best documentaries about Oppenheimer
24 best documentaries about Mormons
13 best documentaries about UFO
10 best documentaries about the Zodiac Killer
10 best documentaries about Fleetwood Mac
12 best documentaries about Ancient Egypt
10 best amazon rainforest documentaries
10 best documentaries about Adolf Hitler
10 best documentaries about Michael Jackson
11 best documentaries about appalachia